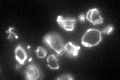
YBR084W
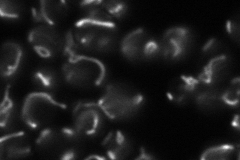
YBR084W
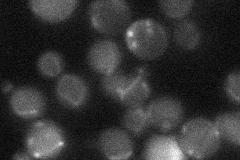
YBR084W
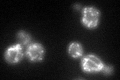
YBR084W
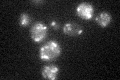
YBR084W

View description
Mitochondrial C1-tetrahydrofolate synthase, involved in interconversion between different oxidation states of tetrahydrofolate (THF); provides activities of formyl-THF synthetase, methenyl-THF cyclohydrolase, and methylene-THF dehydrogenase
Localization:
Intensity:
Fold change:
Significance:
-
C’ GFP library in SD
mitochondria69.9 -
N' NOP1pr-GFP in SD
mitochondria63.5126 -
N' TEF2pr-mCherry in SD

Blank4.0169 -
N' NATIVEpr-GFP in SD
cytosol,mitochondria20.751 -
N' TEF2pr-VC and Cyto-VN in SD

#N/A0 -
C’ GFP library in SD+DTT
mitochondria54.40.77No -
C’ GFP library in SD+H2O2

mitochondria53.360.76No -
C’ GFP library in Starvation Media
mitochondria27.240.38Yes -
C’ GFP library on the background of Pup2-DaMP

mitochondria -
C’ GFP library on the background of CCT mutant

mitochondria64.08870.916681No
